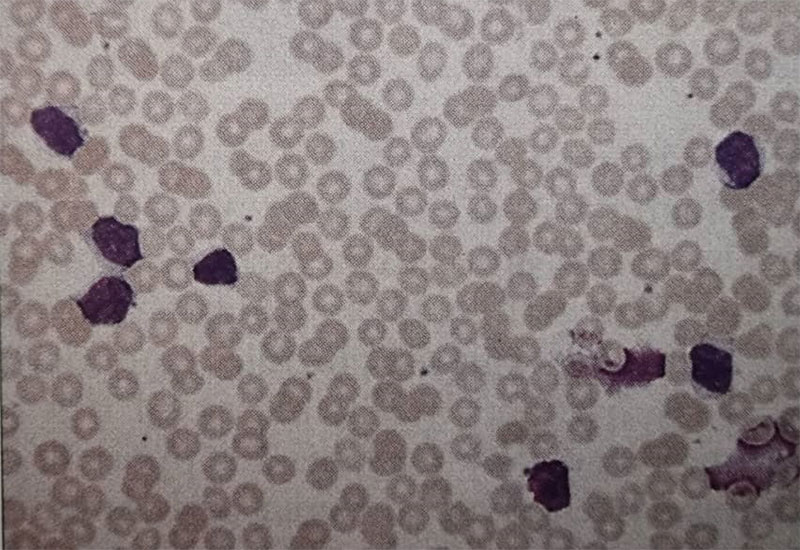
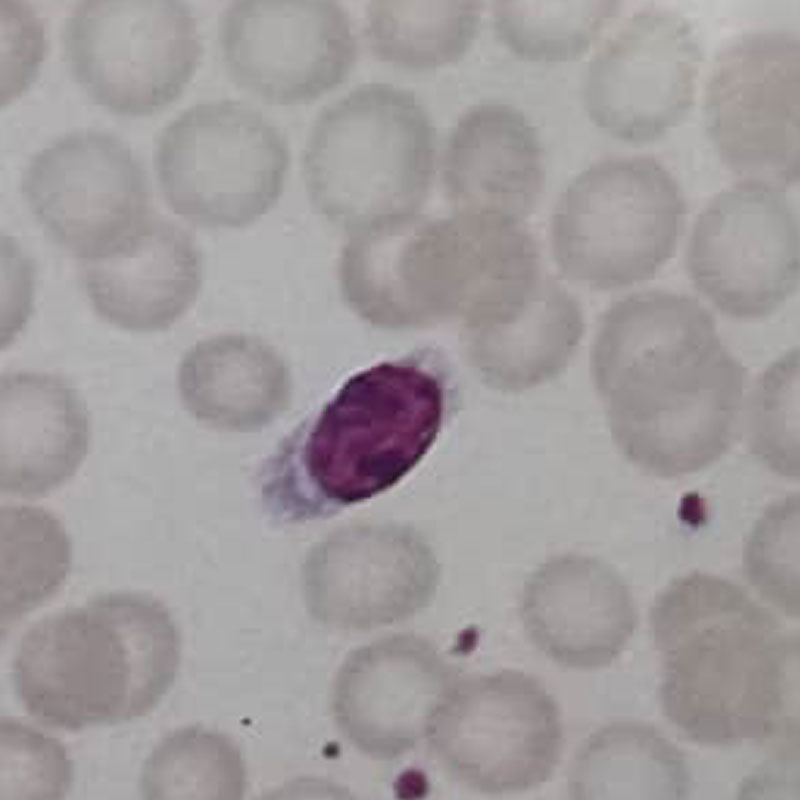

مطالعه موردی بیمار شماره 60، تشخیص شما چیست؟
شرح حال بیمار
یک مرد ۷۶ ساله با بثوراتی (rash) شدیداً دردناک و خارشدار در ناحیهی پایین قفسهی سینه به یک مرکز درمانی مراجعه کرد (تصاویر 60a,60b)
نتیج آزمایش شمارش کامل خون او به شرح زیر است:
- Hb: 1 g/dl
- WBC: 76 × 10⁹/l (لنفوسیتها 91٪، نوتروفیلها 8٪)
- Platelets: 117 × 10⁹/l
در معاینه همچنین لنفادنوپاتی منتشر و بزرگی قابل لمس طحال مشاهده شد.

سوالات و پاسخها
1. با توجه به ظاهر ضایعات پوستی در تصاویر (a60 و b60)، تشخیص بیماری پوستی (درماتولوژی) چیست و درمان مناسب این وضعیت چه میباشد؟
بثورات پوستی، تظاهرات تیپیک زونا (هرپس زوستر) هستند. این بیماری باید با دوزهای بالای آسیکلوویر، ترجیحاً به صورت داخلوریدی درمان شود.
2. چه ناهنجاریای در گسترش خون محیطی بیمار دیده میشود (شکل 60c). تشخیص هماتولوژیک چیست؟
گسترش خون محیطی بیمار افزایش تعداد سلولهای لنفوئیدی بالغ را نشان میدهد و همچنین تعداد زیادی سلول آسیبدیده یا «اسمیر سل» دیده میشود. سلولهای مشابه در مغز استخوان نیز دیده میشوند (شکل 60d)
این یافتهها نشاندهندهی لوسمی لنفوسیتی مزمن (CLL) هستند.
3. چه درمانهای پایهای برای وضعیت خونی او در دسترس هستند؟
این بیماران به علت کاهش غیرطبیعی سطح آنتیبادیها (هیپوگاماگلوبولینمی) در معرض افزایش خطر عفونت هستند و ممکن است نیاز به مراقبت حمایتی و درمان عوارضی مانند کمخونی همولیتیک ایمنی و ترومبوسیتوپنی ایمنی داشته باشند. بسیاری از بیماران اصلاً نیاز به درمان ندارند و باید فقط تحت نظر گرفته شوند.
بیماری پیشرونده ابتدا با تکداروی شیمیدرمانی (مثلاً کلرامبوسیل) درمان میشود، اما بیمارانی که بیماری حجیم دارند یا بیماریشان پیشرفت کرده و دچار نارسایی مغز استخوان شدهاند، ممکن است نیازمند درمان ترکیبی باشند.
داروهای جدیدتر، مانند فلودارابین و ۲-کلرودئوکسیآدنوزین در حال بررسی هستند. اسپلنکتومی و رادیوتراپی برای غدد لنفاوی حجیم از اشکال دیگر درمان میباشند.
4. چه واریانتهایی از این بیماری هماتولوژیک شناخته شدهاند؟
واریانتهای لوسمی لنفوسیتی مزمن شامل موارد زیرند:
- CLL نوع B (مانند این بیمار) که پیشآگهی خوبی دارد (۱۰ سال یا بیشتر).
- CLL نوع T (شکل 60e) که نادر است، پاسخ ضعیفتری به درمان میدهد و اغلب پوست را درگیر میکند.
- لنفوم طحالی با لنفوسیتهای پرزدار (SLVL)، (شکل 60f) که اغلب با پاراپروتئین همراه است و به اسپلنکتومی پاسخ خوبی میدهد.
- لوسمی پرولنفوسیتی نوع سلول های B که با سلولهای بزرگ تر دارای هستک (nucleoli) مشخص میشود (شکل 60g) و ممکن است در بیماران با CLL تکامل یابد یا بهصورت اولیه ظاهر شود. شمارش WBC معمولاً بهطور قابلتوجهی بالا است، اسپلنومگالی شایع است و پاسخ به درمان اغلب ضعیف میباشد.
- لوسمی سلول موئی (Hairy Cell Leukemia) شکل 60h که معمولاً از نوع سلول های B است ولی گاهی سلول های T نیز دیده میشود.
- لنفوم فولیکولار(شکل 60i) که خون محیطی را درگیر میکند و میتواند ظاهری مشابه ایجاد کند.






